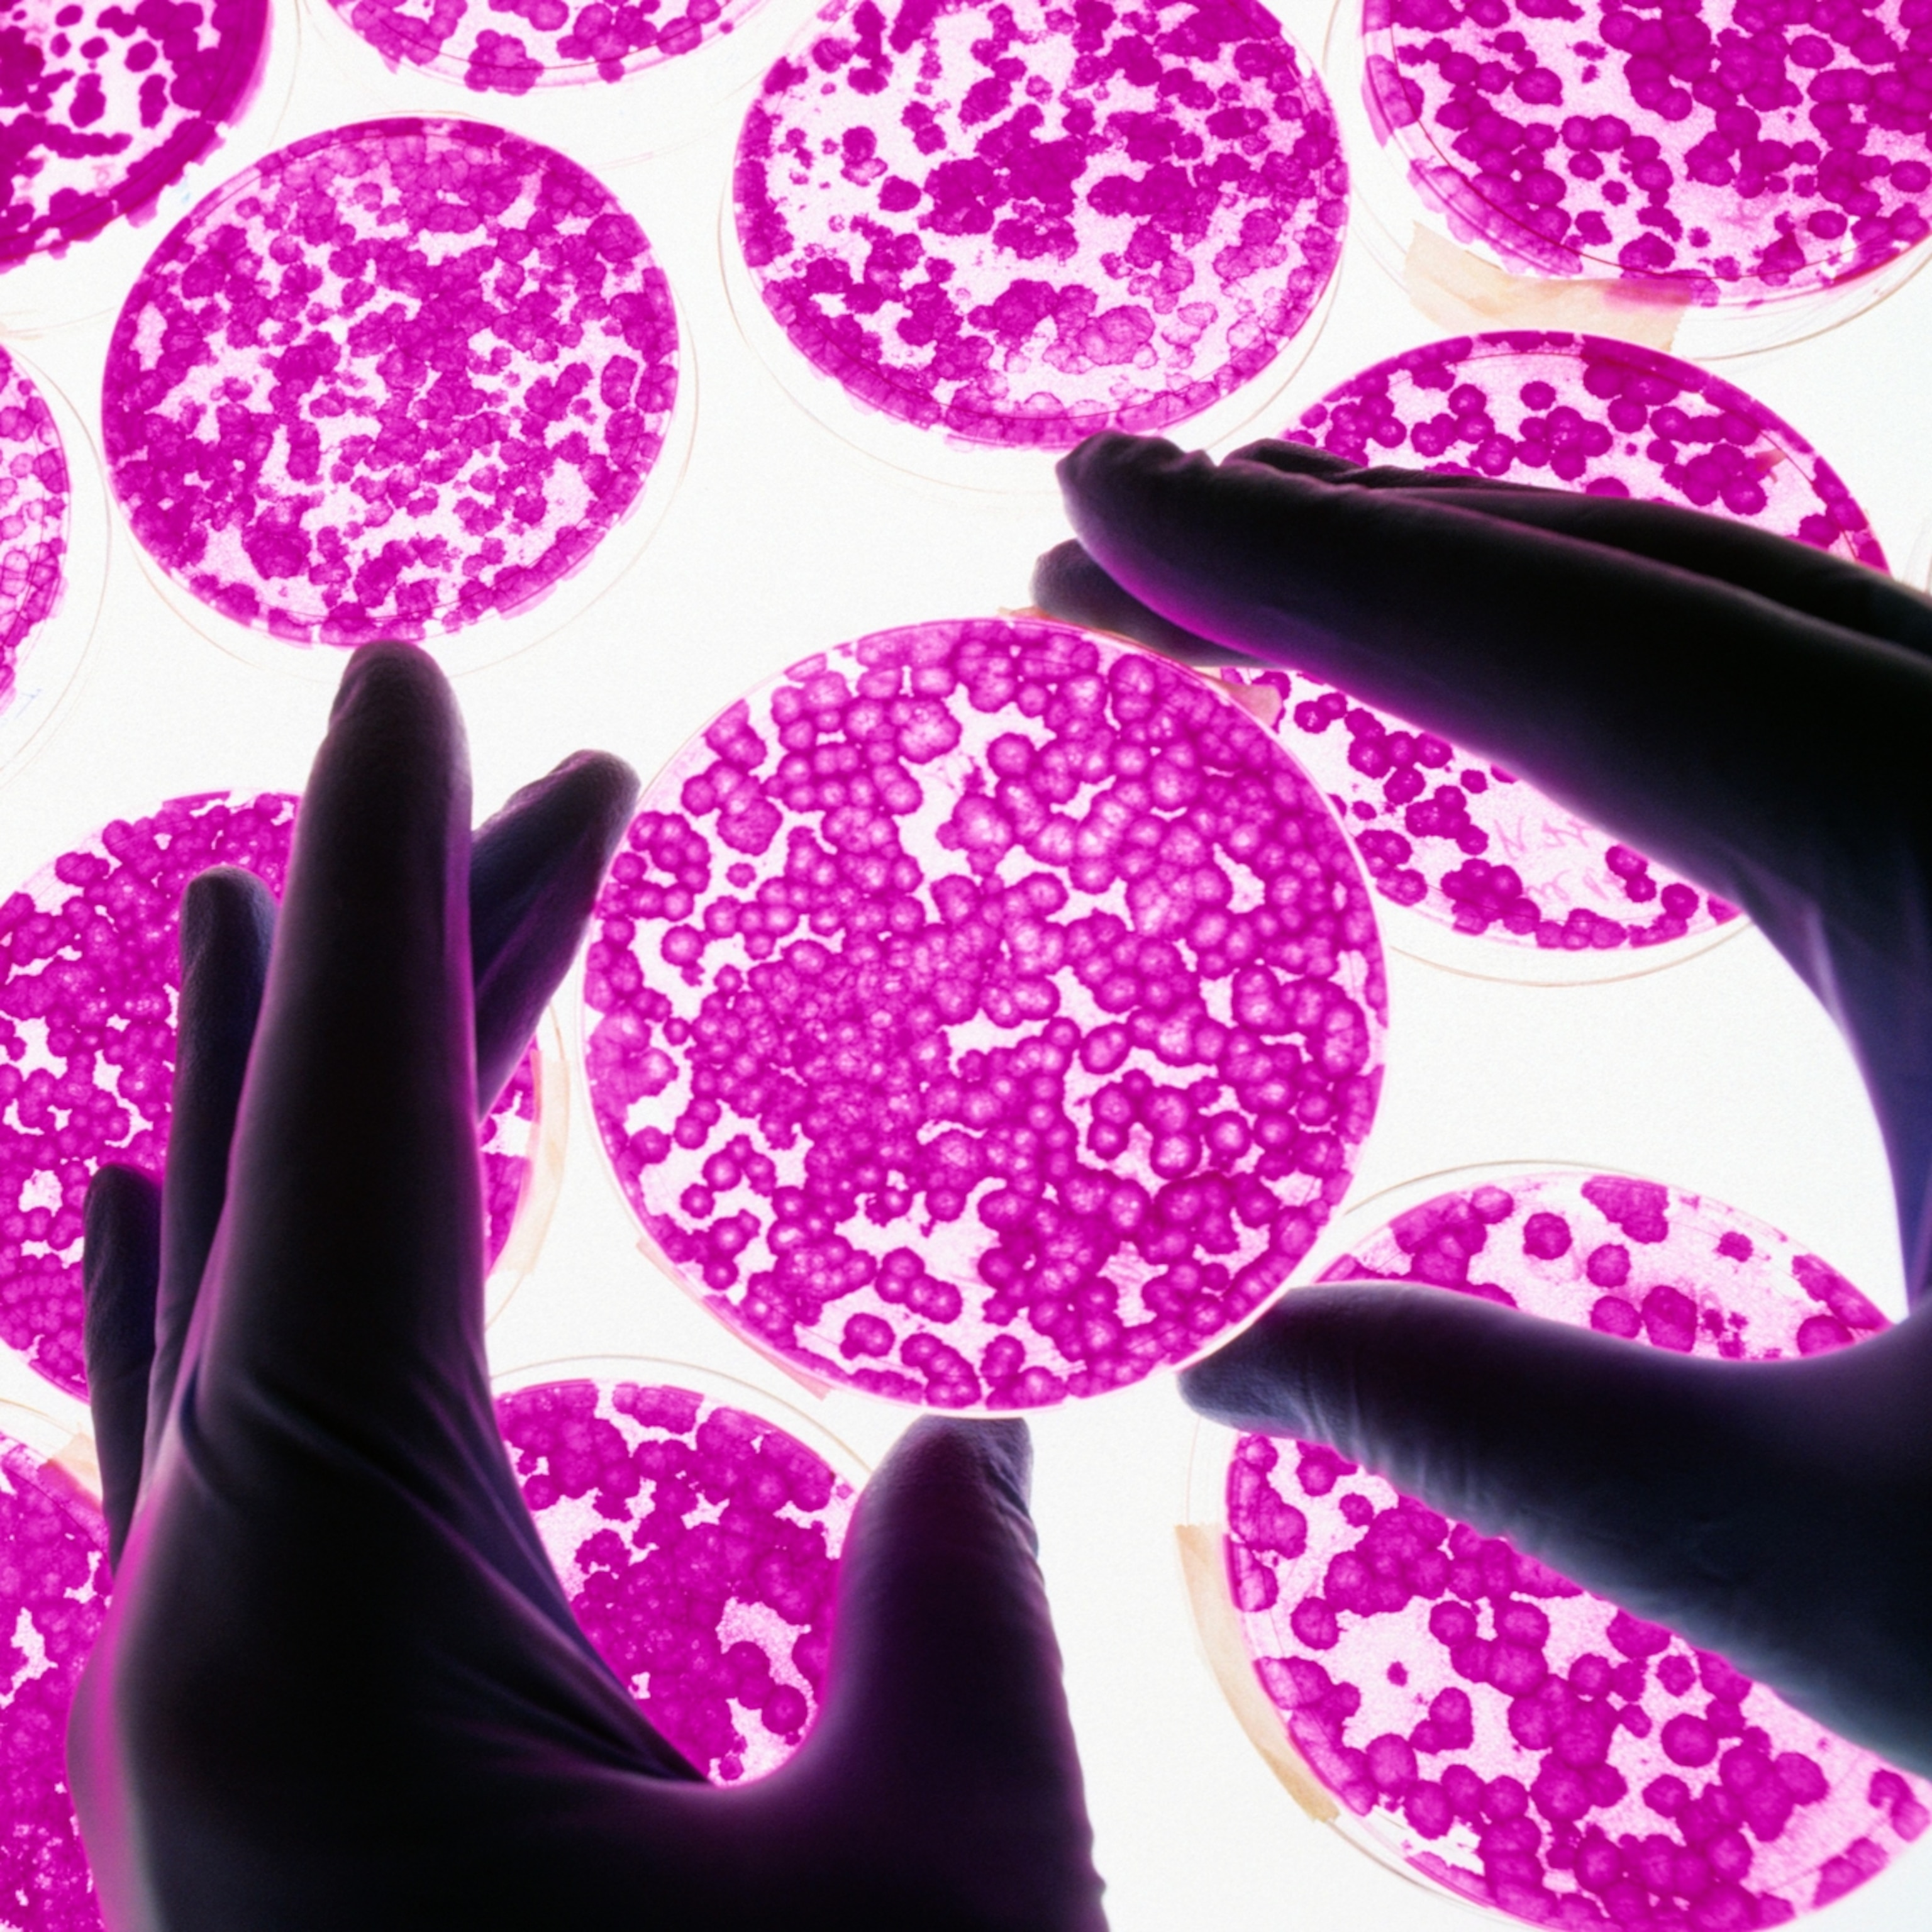

STDs are at a shocking high. How do we reverse the trend?
More than half of new infections were among people aged 15 to 24, and the pandemic lockdowns only tell part of the story. Here’s a look at how we got here—and what we can do about it.

Sexually transmitted infections (STIs) are skyrocketing in the United States, according to the latest data, as gonorrhea, syphilis, and congenital syphilis soared above pre-pandemic levels in 2021. All are preventable and curable if detected early. If that’s the case, why are the numbers increasing?
(Antibiotics Can’t Cure ‘Super-Gonorrhea’—Here's What That Means)
It’s true COVID-19 scrambled and exhausted our healthcare system—but the pandemic explains only part of how we ended up here. Generations-old stigmas, decreased funding of health programs, and limited sex education all contribute.
These factors explain the shocking new STI numbers from the Centers for Disease Control and Prevention. The agency reported that there are at least 2.5 million cases of the four major STIs (the three previously mentioned and chlamydia). Despite having federally funded prevention programs, this number rose 4 percent from 2020.
Those are just reported cases. The CDC notes that a 2018 report found as many as one in five people (about 68 million) have an STI (also known as an STD), so it’s highly likely the actual numbers are even higher. “STIs show no signs of slowing down,” says Leandro Mena, director of CDC’s STI prevention division.


Anyone can get an STI, but cases are not evenly distributed. Half were among teens and young adults, ages 15 to 24. Thirty-one percent of all cases of chlamydia, gonorrhea, and syphilis were among Black people, even though they make up only 12 percent of the U.S. population. Men who have sex with men (MSM) are also disproportionately affected. Almost 40 percent of MSM reporting syphilis had also been diagnosed with HIV.
(Nat Geo predicted a rise in STI numbers last year.)
These disparities are stark, but it doesn’t mean people outside these groups have nothing to worry about. In fact, Mena says anyone who is sexually active should “routinely get tested, at least once a year—especially if you are changing partners, [and] before you start a relationship.”
Syphilis is a great example of why we need to take precautions. Syphilis was relatively recently thought to be on the cusp of eradication, but it surged 32 percent from 2020 to 2021. When a woman has syphilis, she can pass congenital syphilis to her baby—but this is preventable through early detection, says Kristen Batstone, a policy expert at the National Women's Health Network.
Experts in health policy and infectious disease doctors tell us what to take away from this report and how we can reverse the trend.
How’d we get here?
We are learning more about the far-reaching effects of the pandemic, and rising STI numbers are one significant way it has impacted the health of Americans.
Although the relationship between the pandemic and STIs might not be immediately clear, the cause and effect is relatively simple: At the height of the pandemic, personnel and resources like medical supplies were diverted to fight COVID-19. As a result, STI screening, treatment, and prevention were put on hold or limited. Doctors were addressing urgent health needs, which, in some cases, meant overlooking things like STI screening. People also lost their jobs and their health care, making STI screening even harder to get.
“What COVID did reveal to us is that we have gaps within our healthcare system and our public health,” says Renata Sanders, a physician with the American Sexual Health Association and associate professor at Johns Hopkins School of Medicine. “Those gaps really intersect with health disparities that exist in populations that are often most impacted by STDs, including unintended pregnancy, HIV, unstable housing, violence, inadequate insurance, for example.”
(How centuries-old bones may reveal the origins of syphilis.)
The pandemic was a relatively short-term stress on STI care. Experts say the CDC’s new report isn’t surprising, given the long-term trend of STI cases steadily increasing for a decade.
Local health agencies are responsible for implementing care suited for their communities, but they rely heavily on federal funding, according to Rebekah Horowitz, director of STI programs at the National Association of County Health Officials. Until recently, the federal budget for STD prevention stayed the same for almost two decades. Horowitz says that while each community has very different needs, local budgets should be at least doubled.
People most in need
Half of the STI cases in the new report were among teens and adolescents. One contributing reason: Some local policies limit sex education. Where that happens, kids are left to find answers about sex from their friends or online. It’s not just youth that could use more guidance, though. Sanders says doctors themselves may not know where to get guidance on who to screen or when to screen for STIs. Without consistent guidance, screening among youth may be overlooked.
Minors need adult consent and financial assistance in a number of ways related to sexual health and monitoring: They need consent for testing and treatment; they need transportation and access to health care; they need insurance; and they need money to pay for care. Asking for help means young people need to know what sexual behaviors put them at risk. And it requires them to take a perhaps even bigger step: asking their parents.
With the stigma around STIs, young people may not even be telling their friends they’re sexually active, let alone their parents. As a result, they may not receive information about how to prevent STIs. All these factors result in risk for unprotected sex, as well as delayed STI diagnosis and treatment, which leads to people spreading STIs unknowingly, Sanders says.
People in the LGBT community face discrimination based on their sexuality, making it even harder for them to get care. Last month, Tennessee rejected federal funding for HIV prevention because it wants more control over who gets the money. Despite MSM being one of the most affected groups, the state wants to focus on HIV transmission to first responders and from mothers to babies.
Native Americans and Black people also deal with racism and a history of being medically mistreated, and many distrust healthcare providers. People who are low income or live in rural areas have less access to care because of affordability or distance. Often, people belong to more than one of these groups, making it much more difficult for them to get care.
There are some things you can do on your own, Mena says: talk to your partners about the plan to manage sexual health. There are resources from American Sexual Health Association and CDC for parents, adolescents, and the LGBT community about how to talk to your partners and navigate stigma, as well as learn about respectful relationships, consent, sexual violence, and of course, STI prevention.
Reversing the trends
Overcoming the decade-long trend of increasing STI rates will require a significant effort, starting with additional funding for public health systems. COVID-19 was useful in showing that state and local governments can quickly organize free testing and treatment—a necessity for those who are low income or uninsured.
Horowitz says she hopes to see local health departments partner with pharmacies and urgent care facilities so people have more options to get screened and treated. Now, there’s huge variability in how providers screen for STIs, she says, so guidelines should be put in place to screen patients more regularly and universally. Doctors should also be given guidelines about what to talk about with their patients, Batstone says.
“Providers are really at the forefront of elevating the importance of sexual health, [and must] not stigmatize sexual health as part of overall health and wellness,” Mena says. He adds that CDC’s goal is to update their STI treatment guidance “more regularly, almost in real time, as new knowledge and new evidence comes out.”
Sean Cahill, director of health policy research at Fenway Health, an LGBT health care organization, points to the Mpox outbreak last year: “We really have to be prepared for infectious disease outbreaks, including STI outbreaks, because you just don't know what could be coming down the pike.”
Mena says “there’s reason for hope”: there’s been success with reducing new HIV infections and herpes. Advancing technology is allowing for easier screening and treatment. Mena says a new medicine is showing promise in trials that will reduce risk of gonorrhea, chlamydia and syphilis taken up to 72 hours after sex. At home testing is becoming more available, and vaccines for bacterial STIs are being developed.